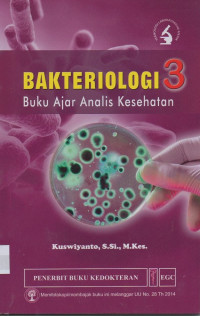
Image of Bakteriologi 3 : Buku Ajar Analis Kesehatan

Detail Cantuman
Pencarian Spesifik
Text
Bakteriologi 3 : Buku Ajar Analis Kesehatan
Tidak Tersedia Deskripsi
Ketersediaan
#
Ruang Koleksi (TLM 004)
Belum memasukkan lokasi
2019110004060
Tersedia
#
Ruang Koleksi (TLM 004)
Belum memasukkan lokasi
2019110004058
Tersedia
#
Ruang Koleksi (TLM 004)
Belum memasukkan lokasi
2019110004059
Tersedia
#
Ruang Koleksi
Belum memasukkan lokasi
2019110004057
Tersedia
Informasi Detail
| Judul Seri |
-
|
|---|---|
| No. Panggil |
-
|
| Penerbit | EGC : ., 2018 |
| Deskripsi Fisik |
-
|
| Bahasa |
Indonesia
|
| ISBN/ISSN |
9789790447912
|
| Klasifikasi |
NONE
|
| Tipe Isi |
-
|
| Tipe Media |
-
|
|---|---|
| Tipe Pembawa |
-
|
| Edisi |
-
|
| Subjek |
-
|
| Info Detail Spesifik |
-
|
| Pernyataan Tanggungjawab |
-
|
Versi lain/terkait
Tidak tersedia versi lain
Informasi
Akses Katalog Publik Daring - Gunakan fasilitas pencarian untuk mempercepat penemuan data katalog







